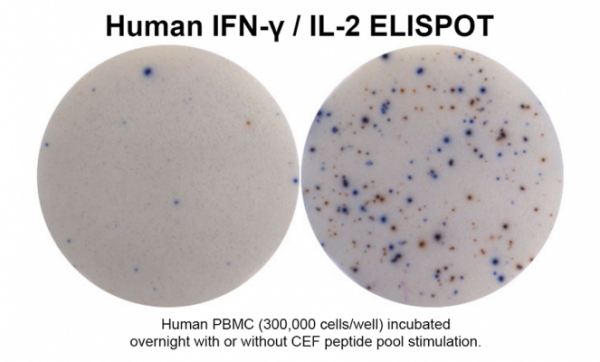
ELISPOT + ImmunoSpot.png

PRODUCT CENTER
特色產(chǎn)品當前位置:首頁 > 特色產(chǎn)品
Th1細胞真的同時分泌IFN-γ和IL-2嗎?在慢性自身免疫疾病中,T細胞是否會逐漸演變?yōu)椤岸喙δ堋保窟@篇2012年發(fā)表于 Cells 的研究,利用CTL雙色ELISPOT技術,在單細胞層面揭示了EAE模型中CD4 T細胞的真實細胞因子表達特征,顛覆了傳統(tǒng)Th1克隆的認知。

文獻標題:Neuroantigen-Specific CD4 Cells Expressing Interferon-γ (IFN-γ) Interleukin (IL)-2 and IL-3 in a Mutually Exclusive Manner Prevail in Experimental Allergic Encephalomyelitis (EAE)
一、研究背景:Th1細胞到底是“全能選手”還是“專業(yè)選手”?
長期以來,Th1細胞被認為是一類共表達IFN-γ、IL-2、IL-3的“經(jīng)典”效應T細胞。然而,大多數(shù)研究依賴于長期培養(yǎng)的T細胞系或克隆,可能引入體外假象。本研究采用CTL雙色ELISPOT,直接在體內(nèi)生理條件下,檢測單個CD4 T細胞的真實細胞因子分泌行為。
二、核心技術:CTL雙色ELISPOT + ImmunoSpot圖像分析
1.雙色ELISPOT:同時捕獲同一細胞分泌的兩種細胞因子(如IFN-γ和IL-2,貨號:hIFNgIL2 ),通過不同顏色底物(AEC紅色 + Vector Blue藍色)顯色。
圖1:雙色ELISPOT原理示意圖
在48小時培養(yǎng)過程中,單個T細胞分泌的細胞因子被膜上預包被的抗體捕獲。通過兩種不同酶標檢測抗體和顯色底物,IFN-γ顯示為紅色斑點,IL-2顯示為藍色斑點。若同一細胞同時分泌兩種細胞因子,則形成綠色(紅+藍疊加)雙陽性斑點。
2.CTL ImmunoSpot分析儀:精準識別單陽性(紅/藍)和雙陽性(綠)斑點,避免人工計數(shù)誤差。

圖2:雙色ELISPOT檢測PLP:139-151特異性CD4細胞的代表性結(jié)果
左圖為培養(yǎng)基對照(無斑點);中圖為抗原刺激后出現(xiàn)紅色(IFN-γ)和藍色(IL-2)單陽性斑點;右圖為軟件分析后的疊加圖,綠色標記雙陽性斑點(占比<5%)。結(jié)果顯示絕大多數(shù)細胞為單陽性。
3.功能親和力(Kf):通過CTL分析軟件自動擬合劑量-反應曲線,評估T細胞對抗原的敏感度。

圖3:不同細胞因子的劑量-反應曲線
隨著抗原肽濃度升高,IFN-γ、IL-2、IL-3的單陽性細胞數(shù)量均呈S形增加,半數(shù)最大刺激濃度(Kf)相近(約5-7 μM),說明產(chǎn)生不同細胞因子的T細胞具有相似的功能親和力。雙陽性比例始終低于8%
√無需細胞固定、無需分泌抑制劑,真實反映細胞生理狀態(tài)
√可檢測低至1:1,000,000的低頻抗原特異性T細胞
√支持48小時連續(xù)捕獲,兼容細胞因子切換現(xiàn)象
三、關鍵發(fā)現(xiàn):單細胞-單細胞因子占主導,多功能T細胞極少
檢測指標 | 結(jié)果 |
IFN-γ + IL-2 雙陽性 | < 5% |
IFN-γ + IL-3 雙陽性 | ~3% |
IFN-γ + IL-4 雙陽性 | < 0.1% |
單陽性細胞比例 | > 95% |
即使在慢性復發(fā)EAE的CNS中,雙陽性比例始終低于6%
四、結(jié)論與啟示
Th1免疫并非由“多功能”T細胞主導,而是由多個單細胞因子亞群協(xié)同完成。
雙色ELISPOT是解析T細胞異質(zhì)性的利器,尤其適用于自身免疫、腫瘤免疫、疫苗研究。
CTL ImmunoSpot平臺,提供從試劑、板子到分析儀器的全套解決方案,支持單/雙/三色ELISPOT、FluoroSpot、酶聯(lián)斑點分析等。
五、產(chǎn)品推薦:CTL雙色ELISPOT試劑盒 + ImmunoSpot分析儀
產(chǎn)品 | 特點 |
Dual-Color ELISPOT Kit | 預包被抗體、雙色底物、陰性對照齊全,即開即用 |
ImmunoSpot S6 Series Analyzer | 支持雙色、三色、熒光斑點自動識別,符合FDA 21 CFR Part 11 |
Functional Avidity Analysis Module | 自動計算Kf值,繪制劑量-反應曲線,助力T細胞功能評價 |
如需了解更多關于Immunospot/CTL品牌產(chǎn)品詳情,可訪問艾美捷科技官方網(wǎng)站( m.zihai029.com)或撥打全國免費服務熱線400-6800-868咨詢。
中國區(qū)特別代理,艾美捷科技有限公司
官網(wǎng):m.zihai029.com
服務熱線:400-6800-868
服務郵箱:sales@amyjet.com

微信掃碼在線客服